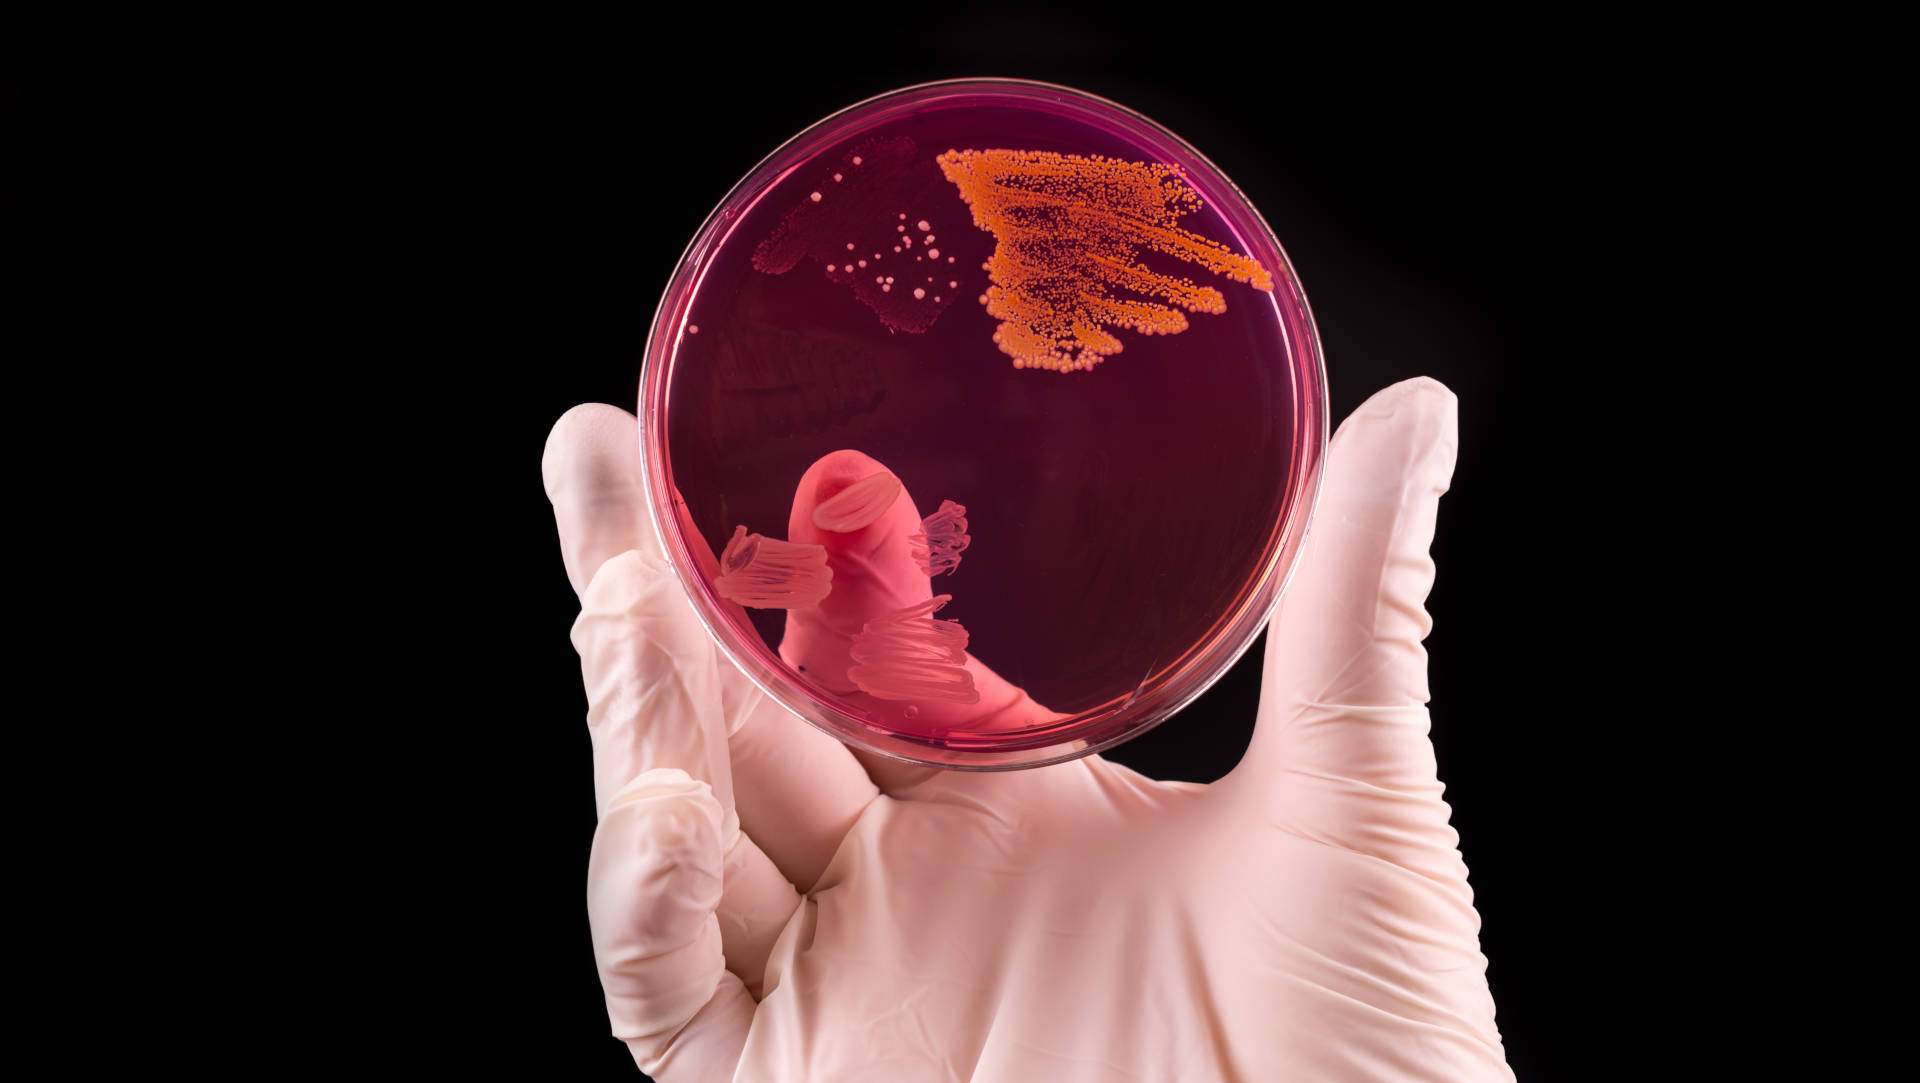

Foundational Trials Collection
After many months of preparation, we're delighted to release our Foundational Trials Collection.
250 critical care contemporary trials are summarised and critiqued in depth.
If you are new to the field, are undertaking exams, or just want to refresh your knowledge, this is an excellent place to start.
added February 17th

Sample Summaries
-
HEMOTION
-
ADRENAL
-
BLING III

RCT
RCT

Commentary
added February 17th

Narrative Reviews
added February 17th

RCT
added February 9th

RCT
added February 9th

RCT
added February 9th
CCR Content

Paper of the Day
ACTiVE Trial
Prof Ary Serpa Neto (Melbourne) presents the results of the ACTiVE trial at CR Down Under 2025 in melbourne. ACTiVE investigates automated closed-loop ventilation in critically ill adults. Prof Danny McAuley (Belfast) delivers an independent editorial. Carol Hodgson (Melbourne) chairs a panel discussion between Anais Charles-Nelson (Melbourne), Shay McGuinness (Auckland) and Matthew Semler (Nashville).
added January 22nd
Trialists' Summary
Prof Ary Serpa Neto (Melbourne) summaries the ACTiVE trial, presnted at CCR Down Under 2025 in Melbourne
Papers
- Sinnige. Effect of Automated Closed-Loop Ventilation vs Protocolized Conventional Ventilation on Ventilator-Free Days in Critically Ill Adults. A Randomized Clinical Trial. JAMA 2025;epublished December 8th
- Editorial: Sklar. Automated Modes to Improve Mechanical Ventilation Outcomes—The Ghost in the Machine. JAMA 2025;epublished December 8th
CCR Meeting Talks
After 14 meetings, we have a huge collection of superb presentations. We'll showcase them here, one at a time.
CCR18
EOLIA Trial
Prof Niall Ferguson (Toronto) presents the EOLIA trial, investigating extracorporeal membrane oxygenation (ECMO) in severe acute respiratory distress syndrome
added January 22nd









